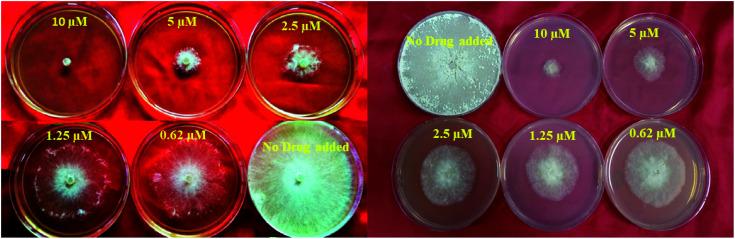
https://cdn.ncbi.nlm.nih.gov/pmc/blobs/fba7/9425831/8b8511ab5ec1/d2ra04465j-f3.jpg

具有对……有良好抗真菌活性的苯并噻唑连接的双三唑基结构异构体的合成
Synthesis of benzothiazole-appended bis-triazole-based structural isomers with promising antifungal activity against .
作者信息
Upadhyay Ravindra Kumar, Saini Keshav Kumar, Deswal Nidhi, Singh Tejveer, Tripathi Kailash Pati, Kaushik Parshant, Shakil Najam Akhtar, Bharti Alok Chandra, Kumar Rakesh
机构信息
Department of Chemistry, University of Delhi Delhi-110007 India
Molecular Oncology Laboratory, Department of Zoology, University of Delhi, School of Life Sciences, JNU-Delhi India.
出版信息
RSC Adv. 2022 Aug 30;12(37):24412-24426. doi: 10.1039/d2ra04465j. eCollection 2022 Aug 22.
In order to explore new antifungal agrochemicals, we reported the synthesis of two series 5a-f, 6 and 7a-f, 8 of benzothiazole-appended bis-triazole derivative-based structural isomers using a molecular hybridization approach. The synthesized compounds were tested for fungal growth inhibition against the plant pathogen . All the synthesized compounds showed excellent antifungal activity in their minimum concentrations (10-0.62 μM). Among all the synthetics, compounds 5b (ED: 2.33 μM), 5f (ED: 0.96 μM), and 7f (ED: 1.48 μM) exerted a superior inhibitory effect in comparison to the commercially available fungicide, hexaconazole (ED: 2.44 μM). The binding interactions of the active compounds 5f, 7f, 6, and 8 within the active site of the sterol 14α-demethylase enzyme were studied with the help of molecular docking studies. The studies revealed that these hybrid pharmacophores could be used as an important intermediate to demonstrate new structural isomer-based fungicides.
为了探索新型抗真菌农用化学品,我们报道了使用分子杂交方法合成了两个系列基于苯并噻唑附加双三唑衍生物的结构异构体5a-f、6和7a-f、8。对合成的化合物进行了针对植物病原体的真菌生长抑制测试。所有合成化合物在其最低浓度(10 - 0.62 μM)下均表现出优异的抗真菌活性。在所有合成物中,化合物5b(ED:2.33 μM)、5f(ED:0.96 μM)和7f(ED:1.48 μM)与市售杀菌剂己唑醇(ED:2.44 μM)相比,具有更强的抑制作用。借助分子对接研究,对活性化合物5f、7f、6和8在甾醇14α-脱甲基酶活性位点内的结合相互作用进行了研究。研究表明,这些杂合药效团可作为展示新型基于结构异构体的杀菌剂的重要中间体。